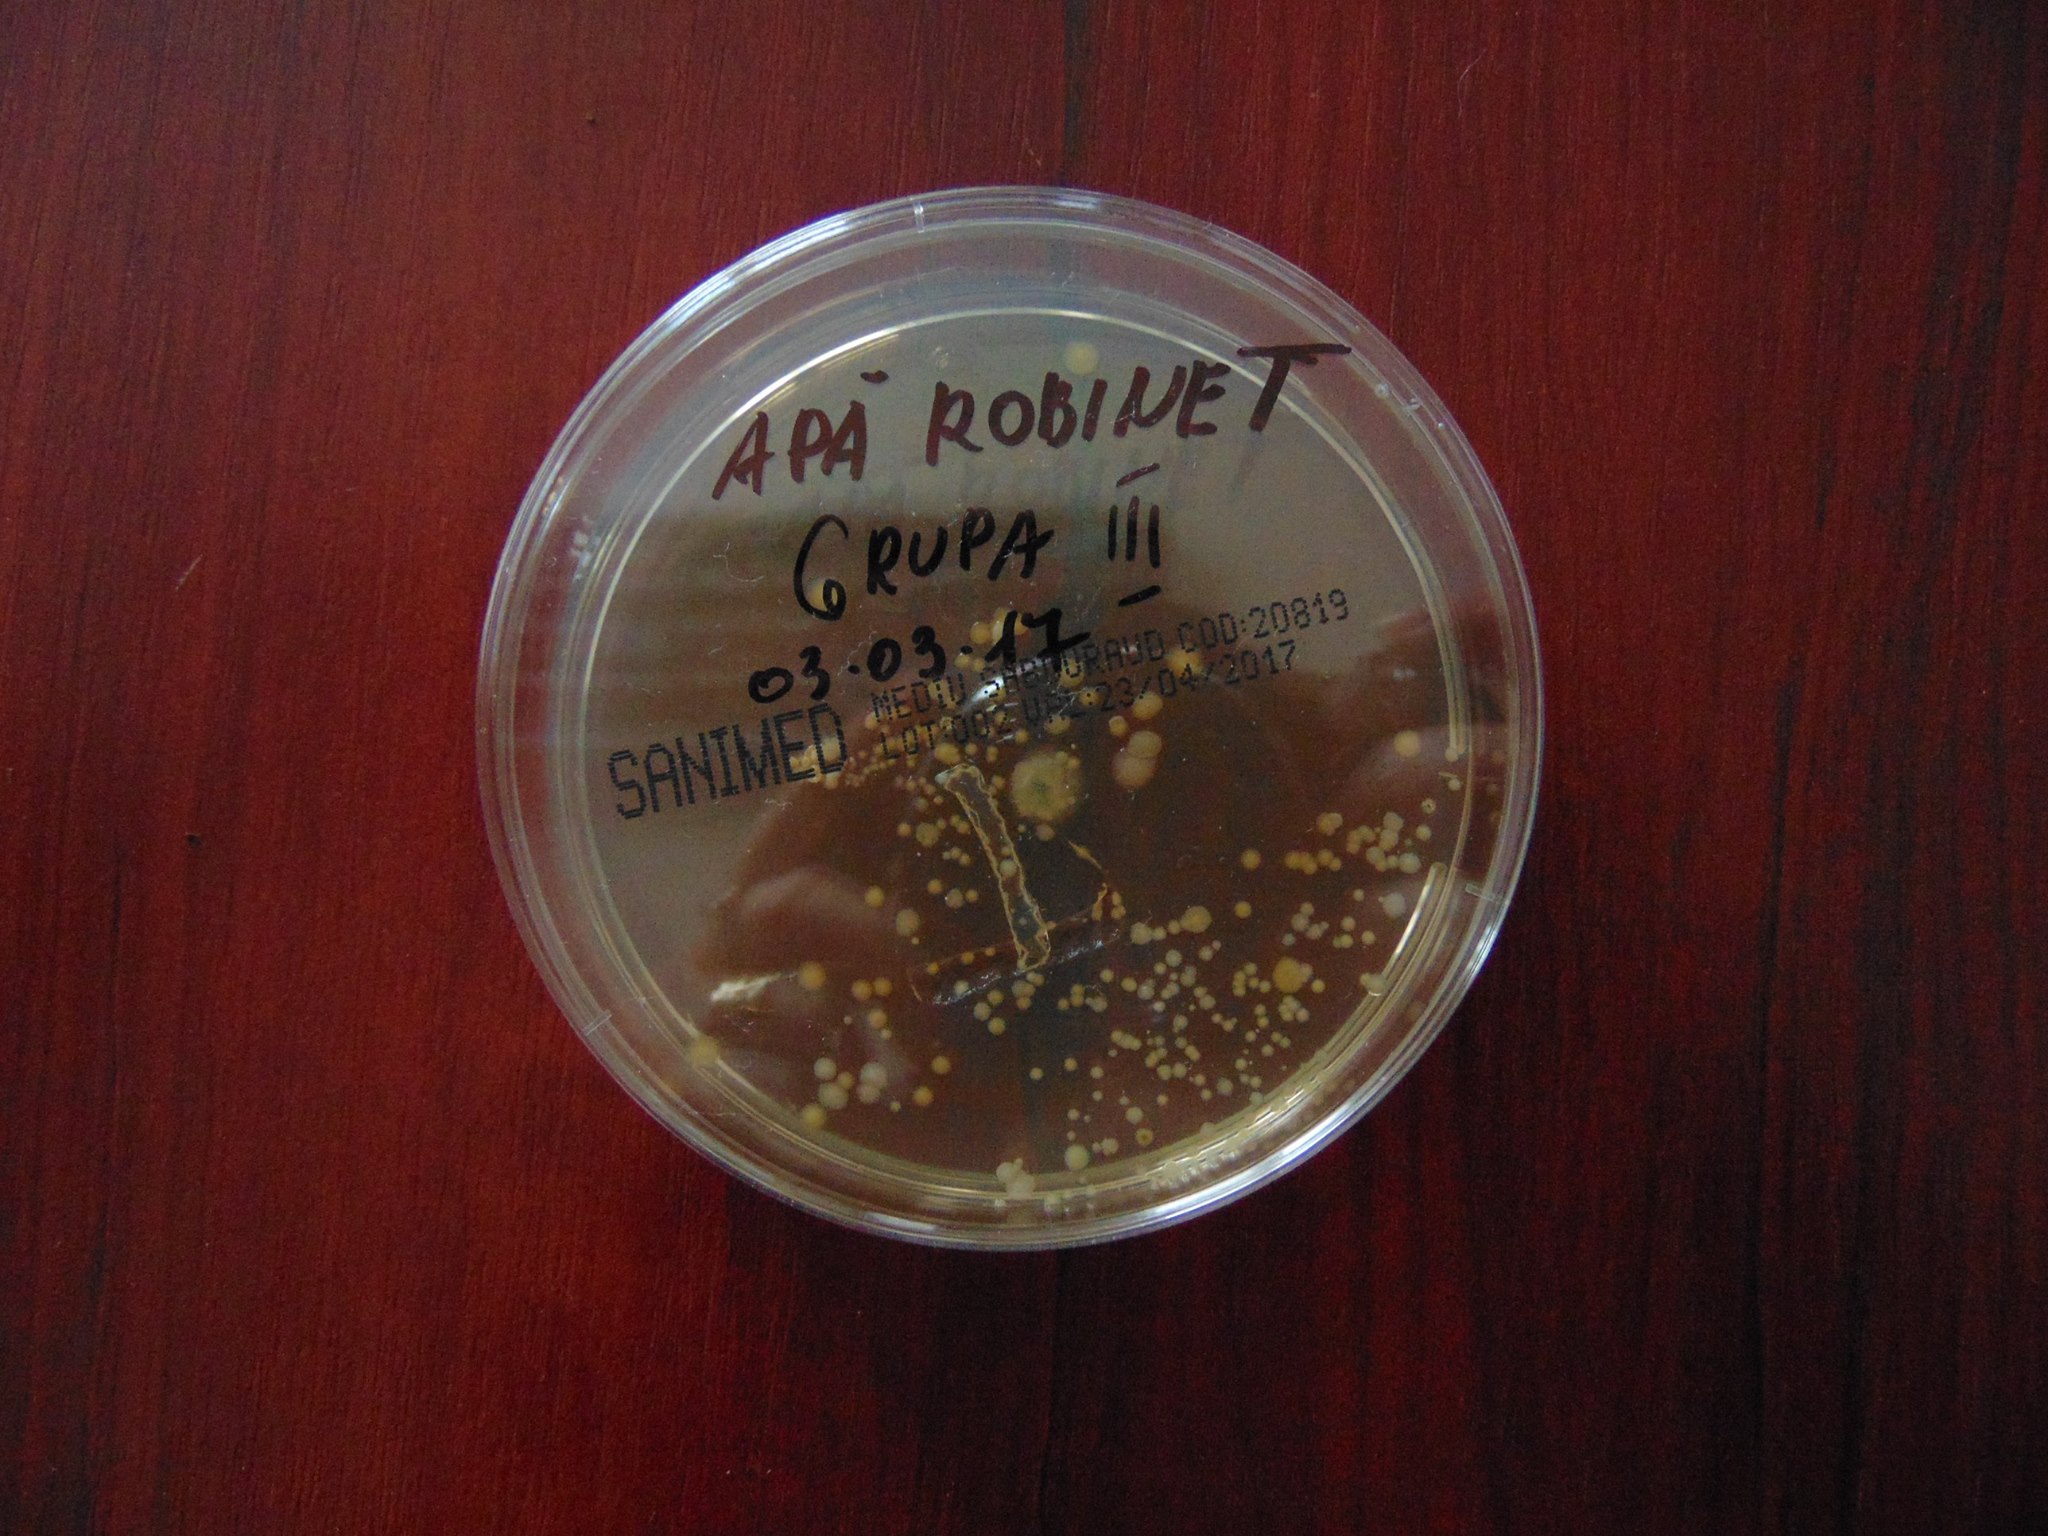

Proiectul MICROWORLD și-a propus promovarea științelor (fizica, chimia, biologia) în rândul elevilor pentru dobândirea abilităților practice și încurajarea pasiunii pentru domeniul microbiologiei.
„Din punctul de vedere al coordonatorului proiectului, MICROWORLD este un proiect care si-a atins obiectivele, antrenând un număr mare de elevi și profesori de la cinci instituții școlare ieșene, care au desfășurat activități și au obținut rezultate pe măsura efortului depus. Proiectul a permis elevilor participanți să prepare culturi bacteriene și fungice pe plăci Petri, să le vizualizeze la microscop și sub îndrumarea unui lector specializat și a muzeografului să experimenteze singuri – modalitate care în alt context ar fi fost dificilă pentru ei.” (dr. Monica Nănescu – muzeograf, coordonator proiect)
Finanțare: 9.000 lei
Echipa de proiect:
– dr. Monica Nănescu – muzeograf, coordonator proiect;
– dr. Oana Florescu – muzeograf, asistent proiect;
– dr. Coralia Costaș – muzeograf, membru în echipa de implementare a proiectului;
– ec. Maria Caras – responsail financiar.
– Iulia Caraiman – conservator, membru în echipa de implementare a proiectului.